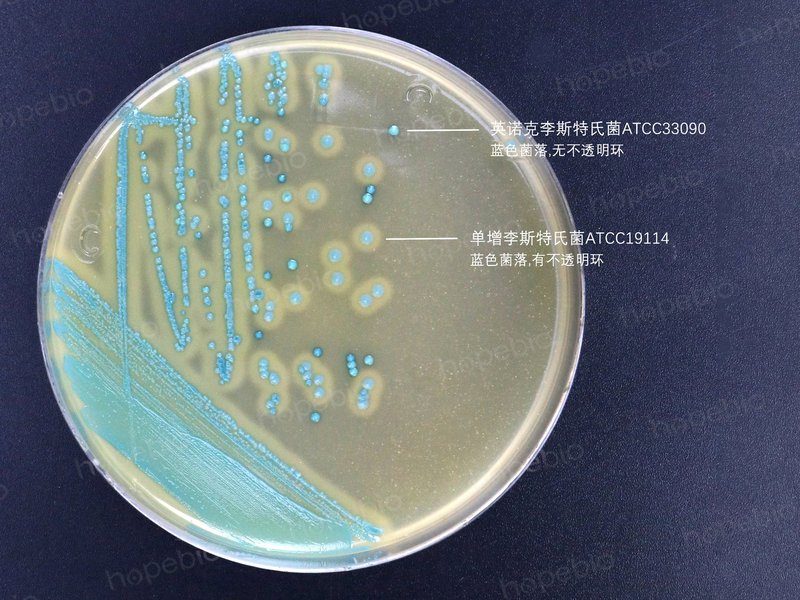

李斯特氏菌显色平板(9cm)/用于李斯特氏菌的显色培养,单增李斯特氏菌显蓝色,外围有一不透明环


![]()
-
念珠菌显色培养基
WJ6509 | 见证书
-
LPM琼脂/用于单增李斯特氏菌的分离培养(FDA标准)
HB4189 | 见证书
-
UVM培养基/用于李氏菌的增菌培养
HB4195 | 见证书
-
MFB培养基/用于李斯特氏菌的选择性增菌培养
HB4193-2 | 见证书
-
SIM生化管/用于单增李斯特氏菌的生化
GB100 | 见证书
-
EB增菌液/用于单增李斯特氏菌选择性增菌培养
HB4192 | 见证书
-
单增李斯特氏菌
BNCC185986 | 见详情
-
MH液体试管
BNCC391763 | 见详情
-
中国蓝培养基即用型平板
BNCC391618 | 见详情
-
肉汤培养基G(麦康凯肉汤)
BNCC391158 | 见详情
-
EG肉汤培养基
BNCC390941 | 见详情
-
蛋白瘤胃球菌培养基基础(含纤维二糖)
BNCC389132 | 见详情




70.0
1.0
李斯特氏菌添加剂6.0g、李斯特氏菌抑菌剂1 1ml*5支、李斯特氏菌抑菌剂2 1ml*5支 (已配套,无需另购) 此配方可以进行改良或增加营养成份以获得最佳的结果。
操作步骤 1、按SN标准、GB标准、FDA标准、ISO标准或其它标准制备样品液; 2、把样品液加入李氏增菌肉汤(LB1、LB2)中增菌;或把样品液和Half-Fraser增菌液按照 1:10 的比例混匀,30℃ 培养 24 小时;或其它增菌液中增菌培养; 3、取一环增菌液划线接种到李斯特氏菌显色培养基上,37℃ 培养 24-48 小时。
包装方式
一次性无菌塑料平皿 9cm
保存温度:2-8℃ 质量控制 1.外观 平板呈不透明乳白色培养基。 2.微生物试验 在37℃培养24-48小时:
质控菌株
ATCC
生长情况
菌落颜色
不透明环
单增李斯特氏菌
27853
+++
蓝色
+
绵羊李斯特氏菌
CICC21663
+++
蓝色
+
西尔李斯特氏菌
CICC21617
+++
蓝色
-
金黄色葡萄球菌
25923
++
黄色
-
大肠杆菌
25922
-
-
-
沙门氏菌
14028
-
-
-
典型特征 单增李斯特氏菌 37℃ 培养 24-28 小时,平板上出现蓝色菌落,菌落周围有一不透明环。绵羊李斯特氏菌 37℃ 培养 48 小时,平板上出现蓝色菌落,菌落周围有一不透明环。西尔李斯特氏菌 37℃ 培养 24-48 小时,平板上出现蓝色菌落,菌落周围没有不透明环。在食品检测中绵羊李斯特氏菌非常少见。注意 此培养基仅供实验室使用。
不同细菌在李斯特氏菌显色平板上的生长特征:
李斯特氏菌显色培养基的微生物灵敏度试验:按标签用法制备培养基,接种以下质控菌株,放置37℃需氧培养24-48小时。
以上信息仅供参考,请以实物批次为准!
本公司销售的所有产品仅供实验科研使用,不用于人体及临床诊断。
2. 梯度稀释:制备1:10至1:1000样品匀液
3. 选择性增菌:30℃培养24-48小时(LB1/LB2)
4. 显色平板分离:划线接种后36℃培养24-48小时[5][7]
2. 显色培养基需避光保存,倾注厚度2-3mm以清晰观察不透明环
3. 可疑菌落需通过API 20E等生化鉴定系统确认[2][7]
以上信息仅供参考,请以相应标准的原文为准!